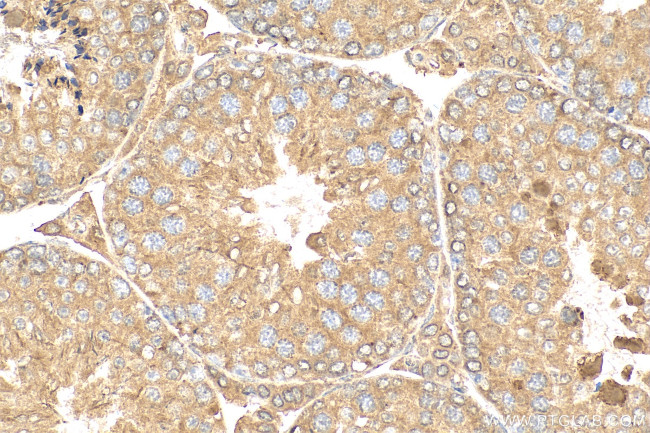
BBOF1 Antibody in Immunohistochemistry (Paraffin) (IHC (P))

Search
Proteintech
BBOF1 Polyclonal Antibody
{{$productOrderCtrl.translations['antibody.pdp.commerceCard.promotion.promotions']}}
{{$productOrderCtrl.translations['antibody.pdp.commerceCard.promotion.viewpromo']}}
{{$productOrderCtrl.translations['antibody.pdp.commerceCard.promotion.promocode']}}: {{promo.promoCode}} {{promo.promoTitle}} {{promo.promoDescription}}. {{$productOrderCtrl.translations['antibody.pdp.commerceCard.promotion.learnmore']}}
产品信息
24337-1-AP
种属反应
宿主/亚型
分类
类型
抗原
偶联物
形式
浓度
规格
纯化类型
保存液
内含物
保存条件
运输条件
产品详细信息
Immunogen sequence: LQQHAMIENQ AGQVEIDKLQ HLLQMKDREM NRVKKLAKNI LDERTEVERF FLDALHQVKQ QILISRKHYK QIAQAAFNLK MRAACTGRTE YPKIRTFDGR EHSTNSVNQD LLEAEKWTHI EGNVDIGDLT WEQKEKVLRL LFAKMNGCPS RKYNQSSRPP VPDYVVSDSG ETKEFGDESK LQDKIFITQQ IAISDSSGEV VLPTIPKEPQ ESDTGTF
靶标信息
Basal body protein required in multiciliate cells to align and maintain cilia orientation in response to flow. May act by mediating a maturation step that stabilizes and aligns cilia orientation. Not required to respond to planar cell polarity (PCP) or flow-based orientation cues.
仅用于科研。不用于诊断过程。未经明确授权不得转售。
篇参考文献 (0)
生物信息学
蛋白别名: Basal body-orientation factor 1; coiled-coil domain containing 176; Coiled-coil domain-containing protein 176; unnamed protein product
基因别名: 2900006K08Rik; AI427784; BBOF1; C14orf45; CCDC176; FBB10; RGD1560978
UniProt ID: (Human) Q8ND07, (Mouse) Q3V079
Entrez Gene ID: (Human) 80127, (Mouse) 72873, (Rat) 500693